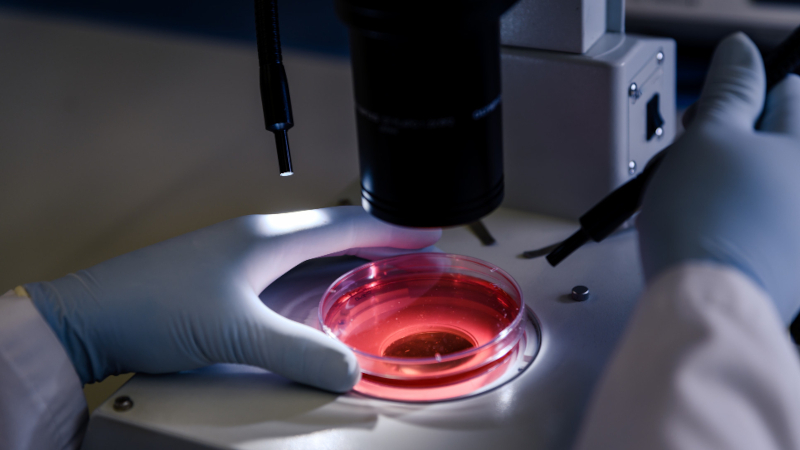

Candidato deve ter doutorado em química orgânica ou bioquímica com experiência em isolamento, purificação e identificação de produtos naturais
Agência FAPESP – O Projeto Temático “Bioluminescência: biodiversidade; origem metabólica; estrutura/função e engenharia de luciferases; empregos em biossensores, bioensaios e bioindicação ambiental” dispõe de uma oportunidade de pós-doutorado em fotobiologia com bolsa da FAPESP. O prazo de inscrição termina no domingo (05/10).
As atividades do projeto são exercidas na Universidade Federal de São Carlos (UFSCar). Contudo, o pós-doutorando trabalhará no Instituto de Química da Universidade de São Paulo (IQ-USP).
O candidato deve ter doutorado em química orgânica ou bioquímica obtido há menos de cinco anos, com sólida formação na área e experiência comprovada em isolamento, purificação e identificação de produtos naturais.
Mais informações sobre a vaga e as inscrições em: www.fapesp.br/oportunidades/8543/.
A oportunidade de pós-doutorado está aberta a brasileiros e estrangeiros. O selecionado receberá Bolsa de Pós-Doutorado da FAPESP no valor de R$ 12.570,00 mensais e Reserva Técnica equivalente a 10% do valor anual da bolsa para atender a despesas imprevistas e diretamente relacionadas à atividade de pesquisa.
Caso o bolsista de PD resida em domicílio fora da cidade na qual se localiza a instituição-sede da pesquisa e precise se mudar, poderá ter direito a um auxílio-instalação. Mais informações sobre a Bolsa de Pós-Doutorado da FAPESP estão disponíveis em www.fapesp.br/bolsas/pd.
Outras vagas de bolsas, em diversas áreas do conhecimento, estão no site FAPESP-Oportunidades, em www.fapesp.br/oportunidades.
Republicar
A Agência FAPESP licencia notícias via Creative Commons (CC-BY-NC-ND) para que possam ser republicadas gratuitamente e de forma simples por outros veículos digitais ou impressos. A Agência FAPESP deve ser creditada como a fonte do conteúdo que está sendo republicado e o nome do repórter (quando houver) deve ser atribuído. O uso do botão HMTL abaixo permite o atendimento a essas normas, detalhadas na Política de Republicação Digital FAPESP.